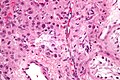

Leydig cell tumour
Jump to navigation
Jump to search
| Leydig cell tumour | |
|---|---|
| Diagnosis in short | |
 Leydig cell tumour. H&E stain. | |
|
| |
| Synonyms | interstitial cell tumour |
|
| |
| LM | cytoplasmic vacuolization, cytoplasm -- clear to eosinophilic, +/-Reinke crystals (cylindrical crystalloid -- eosinophilic cytoplasmic bodies), +/-nucleoli common, round nuclei |
| Subtypes | benign (common), malignant (rare) |
| LM DDx | spermatocytic tumour (testis only), pregnancy luteoma (females only), Sertoli-Leydig cell tumour, Leydig cell hyperplasia |
| IHC | inhibin-alpha +ve, calretinin +ve, melan A +ve |
| Gross | solid, red/tan |
| Grossing notes | orchiectomy grossing |
| Site | testis, ovary (rare) |
|
| |
| Prevalence | uncommon |
| Blood work | +/-elevated testosterone (rarely elevated estradiol) |
| Prognosis | usu. benign, occasionally malignant |
| Clin. DDx | other testicular tumours |
Leydig cell tumour (abbreviated LCT), also known as interstitial cell tumour, is an uncommon benign sex cord-stromal tumour, typically seen in the testis.
Interstitial cell tumour should not be confused with renomedullary interstitial cell tumour.
General
- Arises from the interstitial cell.
- May be associated with increased testosterone.
- Can be malignant in adults.[1]
- May be seen in the ovary.[2]
Clinical:[1]
- +/-Elevated testosterone.
- Rarely elevated estradiol.
- ACTH low.
Gross
- Solid, lobulated.
- Red/tan.
- Typically 3-5 cm.[1]
Image:
Microscopic
Features:[3]
- Vacuolization (cytoplasm) - key feature.
- Cytoplasm - clear to eosinophilic - important.
- Usually eosinophilic.
- Reinke crystals - classic finding, usually not present.
- Cylindrical crystalloid eosinophilic cytoplasmic bodies.
- Nucleoli common.
- Round nuclei.
Features of malignancy in Leydig cell tumours:[4][5]
- Large size (4.7 cm in metastatic LCT vs. 2.6 cm in nonmetastatic LCT[5]).
- Infiltrative margins.
- Lymphovascular invasion.
- Necrosis.
- Nuclear atypia.
- Mitoses (>3/10 HPF).
- High Ki-67 (18.6% in metastatic LCT vs. 1.2% cm in nonmetastatic LCT[5]).
DDx:
- Spermatocytic tumour (previously spermatocytic seminoma) - may have eosinophilic cytoplasm.
- Pregnancy luteoma - occurs during pregnancy, as the name implies.
- Leydig cell hyperplasia.
- Granular cell tumour.[1]
Images
www:
- Leydig cell tumour - several images (upmc.edu).
- Reinke crystals (webpathology.com).
- Reinke crystals (pinterest.com).
- Reinke crystals (pinterest.com). (???)
IHC
- Inhibin-alpha +ve.
- Calretinin +ve.[6][7]
- Melan A +ve.[8]
- AKA MART-1.
- Expressed in melanoma, adrenal tissue, steroid-secreting tumours.
- Vimentin +ve.[1]
- SALL4 -ve (10 of 10 cases).[9]
Sign out
Mass of Right Testicle, Radical Orchiectomy: - Leydig cell tumour. Comment: The tumour consists of polygonal cells with abundant eosinophilic cytoplasm, round nuclei with prominent nucleoli. Features suggestive of malignancy are absent. The tumour stains with calretinin, Melan A and inhibin. It is negative for AE1/AE3, and OCT4. This supports the diagnosis of Leydig cell tumour.
See also
References
- ↑ 1.0 1.1 1.2 1.3 1.4 Al-Agha, OM.; Axiotis, CA. (Feb 2007). "An in-depth look at Leydig cell tumor of the testis.". Arch Pathol Lab Med 131 (2): 311-7. doi:10.1043/1543-2165(2007)131[311:AILALC]2.0.CO;2. PMID 17284120.
- ↑ Yetkin, DO.; Demirsoy, ET.; Kadioglu, P. (Apr 2011). "Pure leydig cell tumour of the ovary in a post-menopausal patient with severe hyperandrogenism and erythrocytosis.". Gynecol Endocrinol 27 (4): 237-40. doi:10.3109/09513590.2010.490611. PMID 20518640.
- ↑ Zhou, Ming; Magi-Galluzzi, Cristina (2006). Genitourinary Pathology: A Volume in Foundations in Diagnostic Pathology Series (1st ed.). Churchill Livingstone. pp. 581. ISBN 978-0443066771.
- ↑ Vasilakaki, T.; Michalis, L.; Skafida, E.; Arkoumani, E.; Delliou, E.; Grammatoglou, X.; Kontovourkis, P.; Papamichail, V. et al. (Jan 2011). "An unusual case of unilateral malignant leydig cell tumour of the testis.". Case Rep Oncol 4 (1): 132-5. doi:10.1159/000326800. PMID 21691571.
- ↑ 5.0 5.1 5.2 Cheville, JC.; Sebo, TJ.; Lager, DJ.; Bostwick, DG.; Farrow, GM. (Nov 1998). "Leydig cell tumor of the testis: a clinicopathologic, DNA content, and MIB-1 comparison of nonmetastasizing and metastasizing tumors.". Am J Surg Pathol 22 (11): 1361-7. PMID 9808128.
- ↑ URL: http://www.antibodybeyond.com/reviews/cell-markers/leydig-cell-marker.htm. Accessed on: 18 May 2010.
- ↑ Bar-Shira Maymon B, Yavetz H, Yogev L, et al. (2005). "Detection of calretinin expression in abnormal immature Sertoli cells in non-obstructive azoospermia". Acta Histochem. 107 (2): 105–12. doi:10.1016/j.acthis.2005.02.002. PMID 15950053.
- ↑ Yao DX, Soslow RA, Hedvat CV, Leitao M, Baergen RN (September 2003). "Melan-A (A103) and inhibin expression in ovarian neoplasms". Appl. Immunohistochem. Mol. Morphol. 11 (3): 244–9. PMID 12966351.
- ↑ Cao D, Li J, Guo CC, Allan RW, Humphrey PA (July 2009). "SALL4 is a novel diagnostic marker for testicular germ cell tumors". Am J Surg Pathol 33 (7): 1065–77. doi:10.1097/PAS.0b013e3181a13eef. PMID 19390421.